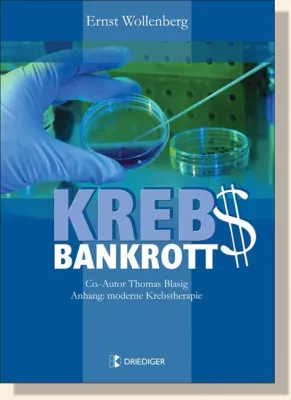
Bild: Mikroparasiten als Verursacher der Krebskrankheit

(openPR) "Werde der, der du bist" steht im Zentrum jeder Heilung. Gleichgültig aus welcher Perspektive dieses Thema betrachtet wird, geht es um diese Botschaft, die bereits auf der Tafel des Tempels von Delphi stand. "Werde der, der du bist" ist auch die Kernaussage des Buches von Anne Devillard. Heidi Brand sprach mit der Autorin und Chefredakteurin der Zeitschrift "Natur & Heilen".
Anne Devillard, welche Botschaft möchten Sie mit Ihrem Buch vermitteln?
Die ganze Aussage des Buches steht eigentlich in seinem Untertitel: "Werde der, der du bist". Auf den ersten Blick scheint es widersprüchlich, zu werden, was man bereits ist, aber der Kern der Botschaft liegt gerade darin: bewusst zu erkennen, wer wir sind, was uns ausmacht, was wir brauchen, um glücklich und gesund zu sein - unserer einmaligen Persönlichkeit entsprechend. Es geht im Laufe unseres Lebens nicht darum, ein anderer zu werden, sondern ein großes Ja zu sich selbst auszusprechen.
Sie sind seit 22 Jahren Chefredakteurin der Monatszeitschrift "Natur & Heilen", die auf dem Gebiet der Naturheilkunde mittlerweile führend ist. Was ist Ihre Hauptmotivation in Ihrer Arbeit?
Wir werden in den Medien ununterbrochen mit negativen Meldungen bombardiert und neigen dazu, zu vergessen, dass wir es sind, die diese unsere Welt gestalten. Mein Anliegen ist es, dass die Leser sich besser fühlen nach der Lektüre der Zeitschrift als vorher. Dass sie Vertrauen und Hoffnung entwickeln und eine Bestätigung bekommen, dass, was sie fühlen und erfahren, richtig ist. Es geht darum, eine Kommunikation von Herz zu Herz herzustellen, damit diese lebensbejahende Botschaft ankommt.
Inwieweit hat Heilung Ihrer Meinung nach mit Spiritualität und Selbsterkenntnis zu tun?
In jedem Menschen pulsiert der angeborene Wille zur (Selbst)Heilung. Allen Heilungsprozessen liegt ein gemeinsamer Nenner zugrunde, nämlich dass Heilung ab dem Moment geschieht, in dem eine Person in Kontakt mit sich und ihrem wahren Kern ist. Deshalb kommt Heilung immer aus unserer Mitte, aus dem Zentrum unseres Selbst, da wo wir in Kontakt mit dem göttlichen Teil in uns sind.
Was wäre demnach Ihre Definition von Gesundheit?
Gesundheit ist viel mehr als eine Abwesenheit von Beschwerden. Sie ist die Art und Weise, wie man in seinem Leben präsent und in Übereinstimmung mit seinem Lebensauftrag ist. In der Sprache der Aborigines gibt es kein Wort für Heilung, man spricht davon "Jemanden wieder glücklich zu machen". Darum geht es: wieder im Einklang mit sich selbst leben und mit einer leichteren Reisetasche durch das Leben wandern und es in vollen Zügen genießen.
Buchtipp:
Anne Devillard:
Heilung aus der Mitte - Werde der, der du bist
398 Seiten, TB, 19,80 EUR
ISBN 978-3-932130-22-
Mehr: http://www.driediger.de